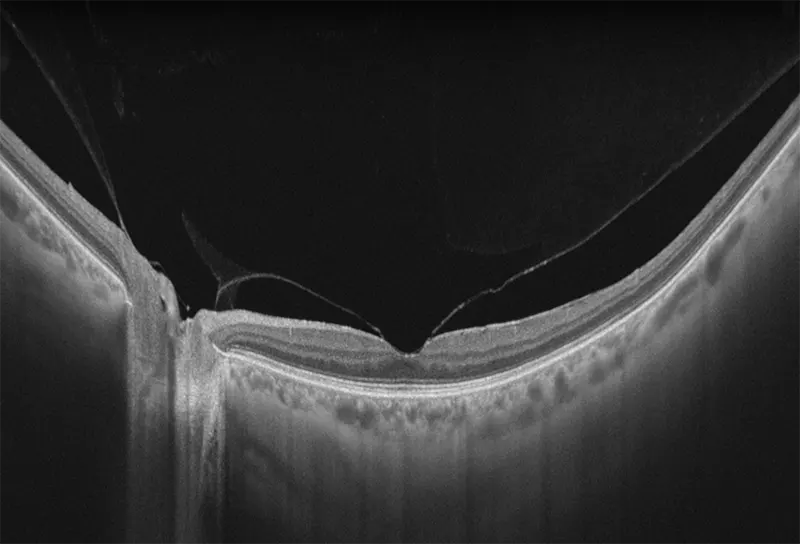

TowardPI Yalkaid 100KHz Full-Range SS-OCT
Características principales del TowardPI Yalkaid 100KHz Full-Range SS-OCT:
- Capacidades de escaneo A de 100 KHz para OCT anterior y posterior
- Profundidad de escaneo de 12 mm, ideal para casos complejos como estafiloma miopía
- Longitud de onda de 1060 nm para una penetración superior a través de opacidades
- Diseño óptico de campo amplio con longitud de escaneo de hasta 16 mm
Descripción general del TowardPI Yalkaid 100KHz Full-Range SS-OCT
Yalkaid (YG-100K) es una nueva generación de SS-OCT con una velocidad de 100 kHz. Su principal ventaja radica en la tecnología SS de rango completo, que permite una profundidad de escaneo de 12 mm para el vítreo, la retina y la coroides, y una extraordinaria de 15 mm para el segmento anterior. La resolución óptica de <6 micrones del dispositivo garantizan una observación detallada de las estructuras anteriores y posteriores.
Con una longitud de onda de 1060 nm, Yalkaid es especialmente beneficioso para escanear pacientes con cataratas y opacidades vítreas. Su carácter invisible minimiza las distracciones por fijación. Además, sus extensos escaneos de línea de 17 mm y escaneos 3D/OCTA de 15 mm cubren un área mayor en comparación con los SD o SS-OCT tradicionales. Yalkaid está equipado con una amplia gama de herramientas de cuantificación y análisis que ayudan enormemente en la práctica clínica y la investigación. Estas características mejoran la precisión diagnóstica y contribuyen a mejores resultados para los pacientes. También tiene un Eyetracking a 60 Hz para mejorar calidad de imagen, reduciendo errores por movimientos oculares.
Características del TowardPI Yalkaid
- El Yalkaid totalmente automático (YG-100K) incorpora una OCT SS-OCT de nueva generación a una velocidad de 100 kHz.
- La tecnología SS de rango completo permite una profundidad de escaneo de 6 mm para vítreo, retina y coroides, y una extraordinaria profundidad de 14 mm para la región anterior.
- La resolución óptica de 3,8 micras garantiza una observación detallada de las estructuras anterior y posterior.
- La longitud de onda de 1060 nm facilita el escaneo en pacientes con cataratas y opacidades vítreas, a la vez que evita la distracción de la fijación gracias a su carácter invisible.
- Las exploraciones 3D/OCTA de 16 mm y 12 mm cubren un área mayor que las OCT SD o SS tradicionales.
- Montaje OCTA: automático o manual
- Resolución axial: 3,8 micras (óptica)
- Resolución lateral: 10 micras (óptica)
Galería OCTs del TowardPi Yalkaid
| Velocidad de escaneo A | 100.000/s |
|---|---|
| Resolución axial | 3,8 micras (óptica) |
| Resolución lateral | 10 micras (óptica) |
| Rango dióptrico | -20 D a +15 D |
| Campo de visión | 56° |
| Longitud de escaneo de la línea posterior | 3-16 mm ajustable |
| Longitud de escaneo de la línea anterior | 3-24 mm ajustable |
| Profundidad de escaneo posterior | 3 mm, 6 mm |
| Profundidad de escaneo anterior | 6 mm, 14 mm |
| Patrón OCTA (retina) | 3 x 3 mm a 12 x 12 mm ajustable |
| Patrón OCTA (anterior) | 6 x 6 mm, 16 x 12 mm, ajustable |
| Posiciones de la línea OCTA | 512-1024 |
| Patrón máximo de escaneo OCTA | 12 x 12 mm (captura única) |